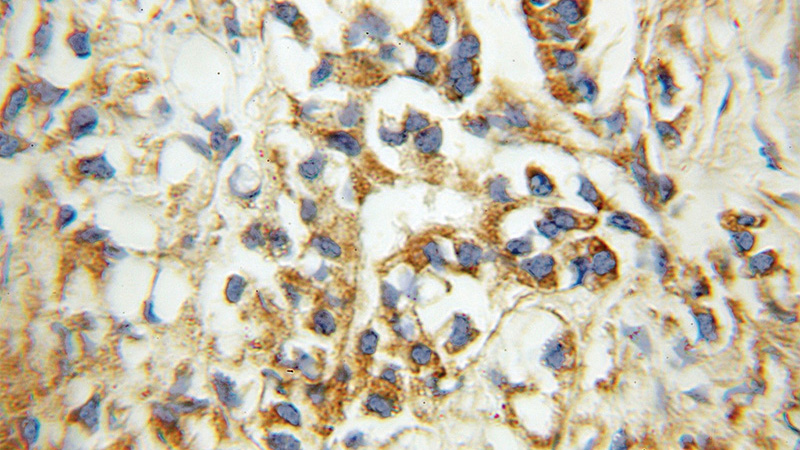
Immunohistochemical of paraffin-embedded human prostate cancer using Catalog No:110293(ECHS1 antibody) at dilution of 1:100 (under 10x lens)

-
Product Name
ECHS1 antibody
- Documents
-
Description
ECHS1 Rabbit Polyclonal antibody. Positive WB detected in human liver tissue, HeLa cells, HepG2 cells, HT-1080 cells, L02 cells, mouse liver tissue, PC-3 cells, rat heart tissue. Positive IP detected in PC-3 cells. Positive IHC detected in human prostate cancer tissue, human liver tissue. Observed molecular weight by Western-blot: 31 kDa
-
Tested applications
ELISA, WB, IHC, IP
-
Species reactivity
Human,Mouse,Rat; other species not tested.
-
Alternative names
ECHS1 antibody; ECoH-1 antibody; Enoyl CoA hydratase 1 antibody; SCEH antibody
-
Isotype
Rabbit IgG
-
Preparation
This antibody was obtained by immunization of ECHS1 recombinant protein (Accession Number: NM_004092). Purification method: Antigen affinity purified.
-
Clonality
Polyclonal
-
Formulation
PBS with 0.1% sodium azide and 50% glycerol pH 7.3.
-
Storage instructions
Store at -20℃. DO NOT ALIQUOT
-
Applications
Recommended Dilution:
WB: 1:500-1:5000
IP: 1:200-1:2000
IHC: 1:20-1:200
-
Validations

human liver tissue were subjected to SDS PAGE followed by western blot with Catalog No:110293(ECHS1 antibody) at dilution of 1:1200

IP Result of anti-ECHS1 (IP:Catalog No:110293, 3ug; Detection:Catalog No:110293 1:500) with PC-3 cells lysate 3000ug.
Immunohistochemical of paraffin-embedded human prostate cancer using Catalog No:110293(ECHS1 antibody) at dilution of 1:100 (under 10x lens)
-
Background
Enoyl-coenzyme A hydratase (ECHS1) is a mitochondrial protein which catalyzes the hydration of 2-trans-enoyl-coenzyme A intermediates to L-3-hydroxyacyl-coenzyme A, playing key role in metabolism of fatty acids in mitochondria. ECHS1 is highly expressed in muscle, liver and fibroblasts. Altered expression of ECHS1 has been considered as a characteristic feature of mitochondria dysfunction. (23275097, 23235493)
-
References
- Yeung AT, Patel BB, Li XM. One-hit effects in cancer: altered proteome of morphologically normal colon crypts in familial adenomatous polyposis. Cancer research. 68(18):7579-86. 2008.
- Addabbo F, Ratliff B, Park HC. The Krebs cycle and mitochondrial mass are early victims of endothelial dysfunction: proteomic approach. The American journal of pathology. 174(1):34-43. 2009.
- Cieniewski-Bernard C, Mulder P, Henry JP. Proteomic analysis of left ventricular remodeling in an experimental model of heart failure. Journal of proteome research. 7(11):5004-16. 2008.
- Roncal-Jimenez CA, Lanaspa MA, Rivard CJ. Sucrose induces fatty liver and pancreatic inflammation in male breeder rats independent of excess energy intake. Metabolism: clinical and experimental. 60(9):1259-70. 2011.
- Lanaspa MA, Cicerchi C, Garcia G. Counteracting roles of AMP deaminase and AMP kinase in the development of fatty liver. PloS one. 7(11):e48801. 2012.
- Sánchez-Lozada LG, Lanaspa MA, Cristóbal-García M. Uric acid-induced endothelial dysfunction is associated with mitochondrial alterations and decreased intracellular ATP concentrations. Nephron. Experimental nephrology. 121(3-4):e71-8. 2012.
- Gong X, Zhu Y, Dong J. Small hepatitis B surface antigen interacts with and modulates enoyl-coenzyme A hydratase expression in hepatoma cells. Archives of virology. 158(5):1065-70. 2013.
- Wang Y, Kou Y, Wang X, Cederbaum A, Wang R. Multifactorial comparative proteomic study of cytochrome P450 2E1 function in chronic alcohol administration. PloS one. 9(3):e92504. 2014.
Related Products / Services
Please note: All products are "FOR RESEARCH USE ONLY AND ARE NOT INTENDED FOR DIAGNOSTIC OR THERAPEUTIC USE"
